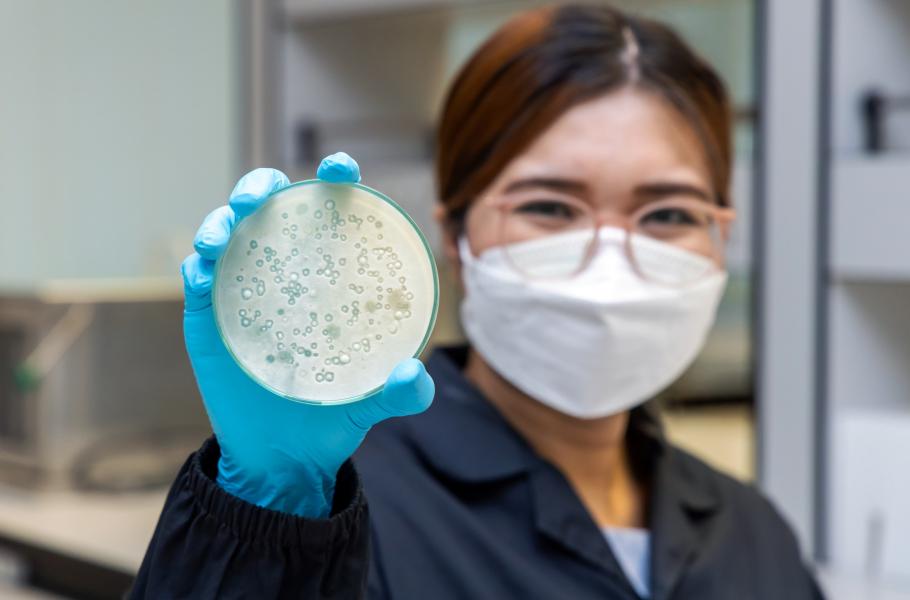

Riziko oteplujícího se světa: Houbové patogeny nebezpečně mutují
Čínský výzkum potvrzuje rostoucí hrozbu houbových infekcí. Jsou nakažlivější, rozvíjejí se rezistence vůči běžně používaným lékům a objevují se i nové druhy patogenů.
Změny klimatu a rostoucí teploty přinášejí dříve neznámé problémy. (ilustrační foto: Shutterstock)
Svět se otepluje a má to důsledky. Některé jsou předem jasné, jiné jsou nepříjemným překvapením. Jedním z těch překvapivějších je rozmach nebezpečných houbových infekcí, kterým se při vyšších teplotách daří. Jak se ukazuje, původci těchto infekcí mutují a stávají se velice nakažlivými a rezistentními vůči běžně používaným lékům.
Podle studie týmu čínských odborníků, kterou v těchto dnech zveřejnil vědecký časopis Nature Microbiology, je takový vývoj velice zneklidňující. Zdá se, že jsme doposud velmi podceňovali nebezpečí, jaké představují nově vzniklé typy houbových patogenů, které se dnes objevují. Už teď mají houbové infekce na svědomí asi 3,75 milionů mrtvých ročně.
Teplo a mutace
Jak uvádějí čínští badatelé, oteplování u těchto patogenů posiluje tvorbu nových mutací. Kvůli tomu se ve zvýšené míře objevují jednak vysoce virulentní typy houbových patogenů, které působí více závažná onemocnění, a také typy, které jsou rezistentní vůči různým používaným léčivům.
Čínský tým prostudoval záznamy o houbových infekcích v 96 čínských nemocnicích mezi lety 2009 a 2019 a ukázalo se, že kromě přibývajícího počtu houbových nákaz u pacientů se také objevují úplně nové infekce, jaké jsme u lidí doposud nezaznamenali. Ve dvou takových případech narazili na různé kmeny rodu Rhodosporidiobolus, který náleží mezi stopkovýtrusné kvasinky.
Experimenty čínských vědců prokázaly, že vyšší teplota může u těchto hub zvyšovat míru mutací, což souvisí s rychlejším rozvojem rezistence vůči lékům. Vyšší teplota může také vést k přechodu z kvasinkové životní formy na vláknitou, zvanou pseudomycelium, která je zodpovědná za nebezpečnější infekce.



